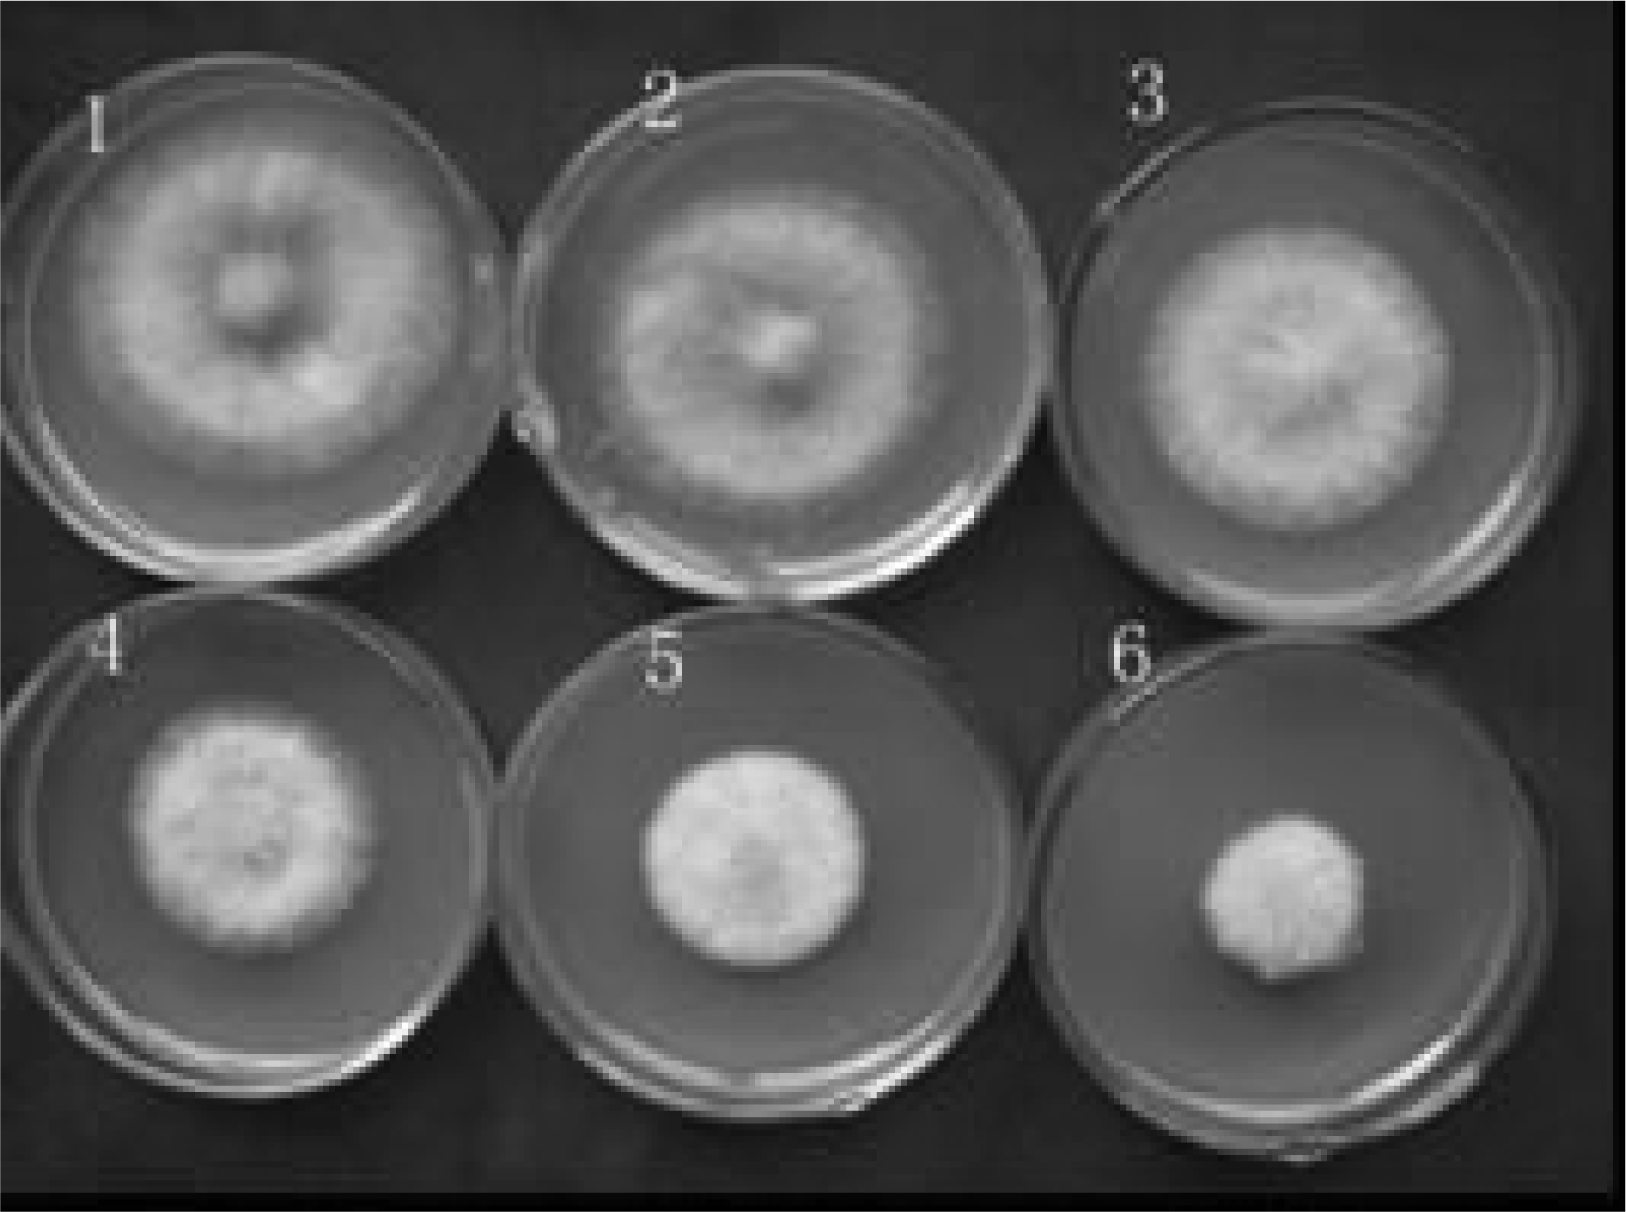

Fusarium Graminearum Growth Inhibition Due to Glucose Starvation Caused by Osthol
Abstract
:1. Introduction
2. Results and Discussion
2.1 Results
2.1.1 Effects of osthol on hyphal growth
2.2.2 Effects of osthol on hyphae morphology
2.2.3 Effects of osthol on hyphal glucose absorption
2.2 Discussion
3. Experimental Section
3.1 Chemicals and fungal strain
3.2 Antifungal activity assays
3.3 Effect of osthol on hyphal morphology
3.4 Preparation of hyphae
3.5 Determining the mycelial of F. graminearum absorbed 14C-labelled glucose
3.6 Determination of reducing sugar
3.7 Determination of N-Acetyl-D-Glucosamine
3.8 Analysis of chitinase
3.9 Analysis of β-1,6-glucanase activity
Acknowledgments
References
- Parry, DW; Jenkinson, P; McLeod, L. Fusarium ear blight (scab) in small grain cereals - a review. Plant Pathol. 1995, 44, 207–238. [Google Scholar] [Green Version]
- Jianxin, W; Mingguo, Z; Yuejian, L; Zhongyin, Y. Dynamics of resistant population of Fusarium graminearum to carbendazim and substitutable fungicide screening. J. Nanjing Agric. Univ. 2002, 25, 43–47. [Google Scholar] [Green Version]
- Dan, W; Huazhi, Y; Yun, Q. The resistance of Fusarium graminearum to Carbendazim in Sichuan. Agrochemicals 2007, 46, 560–562. [Google Scholar] [Green Version]
- Various. Pharmacopoeia of the People’s Republic of China, English Edition ed; Chemical Industry Press: Beijing, P.R. China, 1997; pp. 62–63. [Google Scholar]
- Ou, M. Chinese-English manual of commonly used traditional Chinese medicine; Joint Publishing Co. Ltd.: Hong Kong, 1989. [Google Scholar]
- Yamahara, J; Kozuka, M; Sawada, T; Fujimura, H; Nakano, K; Tomimatsu, T; Nohara, T. Biologically active principles of crude drugs. Anti-allergic principles in “Cnidii monnieri”. Chem. Pharm. Bull. 1985, 33, 1676–1680. [Google Scholar] [Green Version]
- Matsuda, H; Tomohiro, N; Ido, Y; Kubo, M. Anti-allergic effects of Cnidii Monnieri fructus (dried fruits of Cnidium monnierz) and its major component, osthol. Biol. Pharm. Bull. 2002, 25, 809–812. [Google Scholar] [Green Version]
- Liao, JM; Zhu, QA; Lu, HJ; Li, QN; Wu, T; Huang, LF. Effects of total coumarins of Cnidium monnieri on bone density and biomechanics of glucocorticoids induced osteoporosis in rats. Acta Pharmacol. Sin. 1997, 18, 519–521. [Google Scholar] [Green Version]
- Shukla, YN; Srivatava, A. Phytotoxic and antimicrobial constiuents of Argyreia speciosa and Oenothera biennes. Ethnopharmacology 1986, 67, 241–245. [Google Scholar] [Green Version]
- Shi, ZQ; Shen, SG; Xu, LL; Fan, YJ. Inhibition Mechanism of Osthol to Plant Fungus Pathogens. Chin. J. Pest. Sci. 2004, 6, 28–32. [Google Scholar] [Green Version]
- Chaffin, WL; Lopez-Ribot, JL; Casanova, M; Gozalbo, D; MartÌez, JP. Cell wall and secreted proteins of Candida albicans: identification, function and expression. Microbiology and Molecular Biology Reviews 1998, 62, 130–180. [Google Scholar] [Green Version]
- Donzelli, BGG; Harman, GE. Interaction of ammonium, glucose, and chitin regulates the expression of cell wall-degrading enzymes in Trichoderma atroviride strain P1. Appl. Environ. Microbiol. 2001, 67, 5643–5647. [Google Scholar] [Green Version]
- Moniello, G; Richardson, AJ. Effects of coumarin and sparteine on attachment to cellulose and cellulolysis by Neocallimastix frontalis RE1. Appl. Environ. Microbiol. 1996, 62, 4666–4668. [Google Scholar] [Green Version]
- Yuan, WP; Strømhaug, PE. Glucose-induced Autophagy of Peroxisomes in Pichia pastoris Requires a Unique E1-like Protein. Mol. Biol. Cell 1999, 10, 1353–1366. [Google Scholar] [Green Version]
- Yu, SM. Cellular and genetic responses of plants to sugar starvation. Plant Physiol 1999, 121, 687–693. [Google Scholar] [Green Version]
- Dunn, WJ. Autophagy and related mechanisms of lysosome-mediated protein degradation. Trends Cell Biol. 1994, 4, 139–143. [Google Scholar] [Green Version]
- Matsuura, A; Tsukada, M; Wada, Y; Ohsumi, Y. Apg1p, anovel protein kinase required for the autophagic process in Saccharomyces cerevisiae. Gene 1997, 192, 245–250. [Google Scholar] [Green Version]
- Celio, GJ; Mims, CW; Richardson, EA. Ultrastructure and immunocytochemistry of the host-pathogen interface in poinsettia leaves infected with powdery mildew. Can. J. Bot. 2004, 82, 421–429. [Google Scholar] [Green Version]
- Marqueze, A; Kucharski, LC; Da Silva, R. Effects of anoxia and post-anoxia recovery on carbohydrate metabolism in the jaw muscle of the crab Chasmagnathus granulatus maintained on carbohydrate-rich or high-protein diets. J. Exp. Mar. Biol. Ecol. 2005, 332, 198–205. [Google Scholar] [Green Version]
- Miller, GL. Use of dinitrosalicylic acid reagent for the determination of reducing sugar. Anal. Chem. 1959, 31, 426–428. [Google Scholar] [Green Version]
- Ciopraga, J; Gozia, O; Tudor, R; Brezuica, L; Doyle, RJ. Fusarium sp. growth inhibition by wheat germ agglutinin. Biochim. Biophys. Acta-Gen. Subj. 1999, 1428, 424–432. [Google Scholar] [Green Version]
- Elad, Y; Chet, I; Henis, Y. Degradation of plant pathogenic fungi by Trichoderma harzianum. Can. J. Microbiol. 1982, 28, 719–725. [Google Scholar] [Green Version]
- Shi, YM. Introduction of modern plants physiology experiments; Science Press: Beijing, P.R. China, 1999; p. 12. [Google Scholar]

Share and Cite
Shi, Z.; Shen, S.; Zhou, W.; Wang, F.; Fan, Y. Fusarium Graminearum Growth Inhibition Due to Glucose Starvation Caused by Osthol. Int. J. Mol. Sci. 2008, 9, 371-382. https://doi.org/10.3390/ijms9030371
Shi Z, Shen S, Zhou W, Wang F, Fan Y. Fusarium Graminearum Growth Inhibition Due to Glucose Starvation Caused by Osthol. International Journal of Molecular Sciences. 2008; 9(3):371-382. https://doi.org/10.3390/ijms9030371
Chicago/Turabian StyleShi, Zhiqi, Shouguo Shen, Wei Zhou, Fei Wang, and Yongjian Fan. 2008. "Fusarium Graminearum Growth Inhibition Due to Glucose Starvation Caused by Osthol" International Journal of Molecular Sciences 9, no. 3: 371-382. https://doi.org/10.3390/ijms9030371
APA StyleShi, Z., Shen, S., Zhou, W., Wang, F., & Fan, Y. (2008). Fusarium Graminearum Growth Inhibition Due to Glucose Starvation Caused by Osthol. International Journal of Molecular Sciences, 9(3), 371-382. https://doi.org/10.3390/ijms9030371
